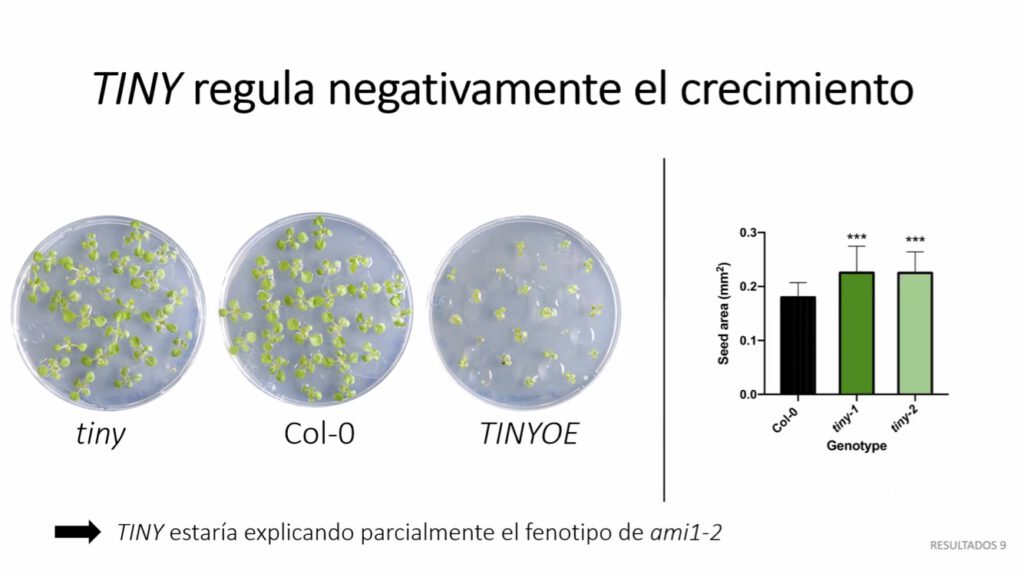

Anything but TINY
Enhorabuena Cristina..! 
On Friday 2nd of July, our Master student, Cristina Molinero Gallego, defended her Master project entitled “Análisis del papel del IAM en el control de TINY y su relación con respuestas a estrés abiótico” very successfully. It was great to see that an idea, which was not more than a vague hint, turned into something that might be the foundation of a whole new project. The entire lab is proud of your work and wishes you all the best for your future career!